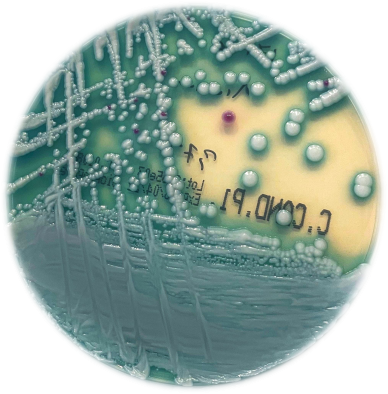

Οδηγίες χρήσης φακέλων αποθήκευσης τρυβλίων
Παρακολουθείστε το παρακάτω video γα να δείτε τον τρόπο αποθήκευσης και συντήρησης των τρυβλίων. Από 07/01/2025 έχουμε ξεκινήσει να σας προμηθεύουμε με τους ειδικούς φακέλους (σακουλάκια) που θα αποθηκεύετε τα τρυβλία στο ψυγείο με ασφάλεια και χωρίς τον κίνδυνο να αφυδατωθούν ή να επιμολυνθούν έως την ημερομηνία λήξης τους . Οι φάκελοι είναι σε τρεις […]
Οδηγίες χρήσης φακέλων αποθήκευσης τρυβλίων Read More »
Νέα, Χρήσιμα videos